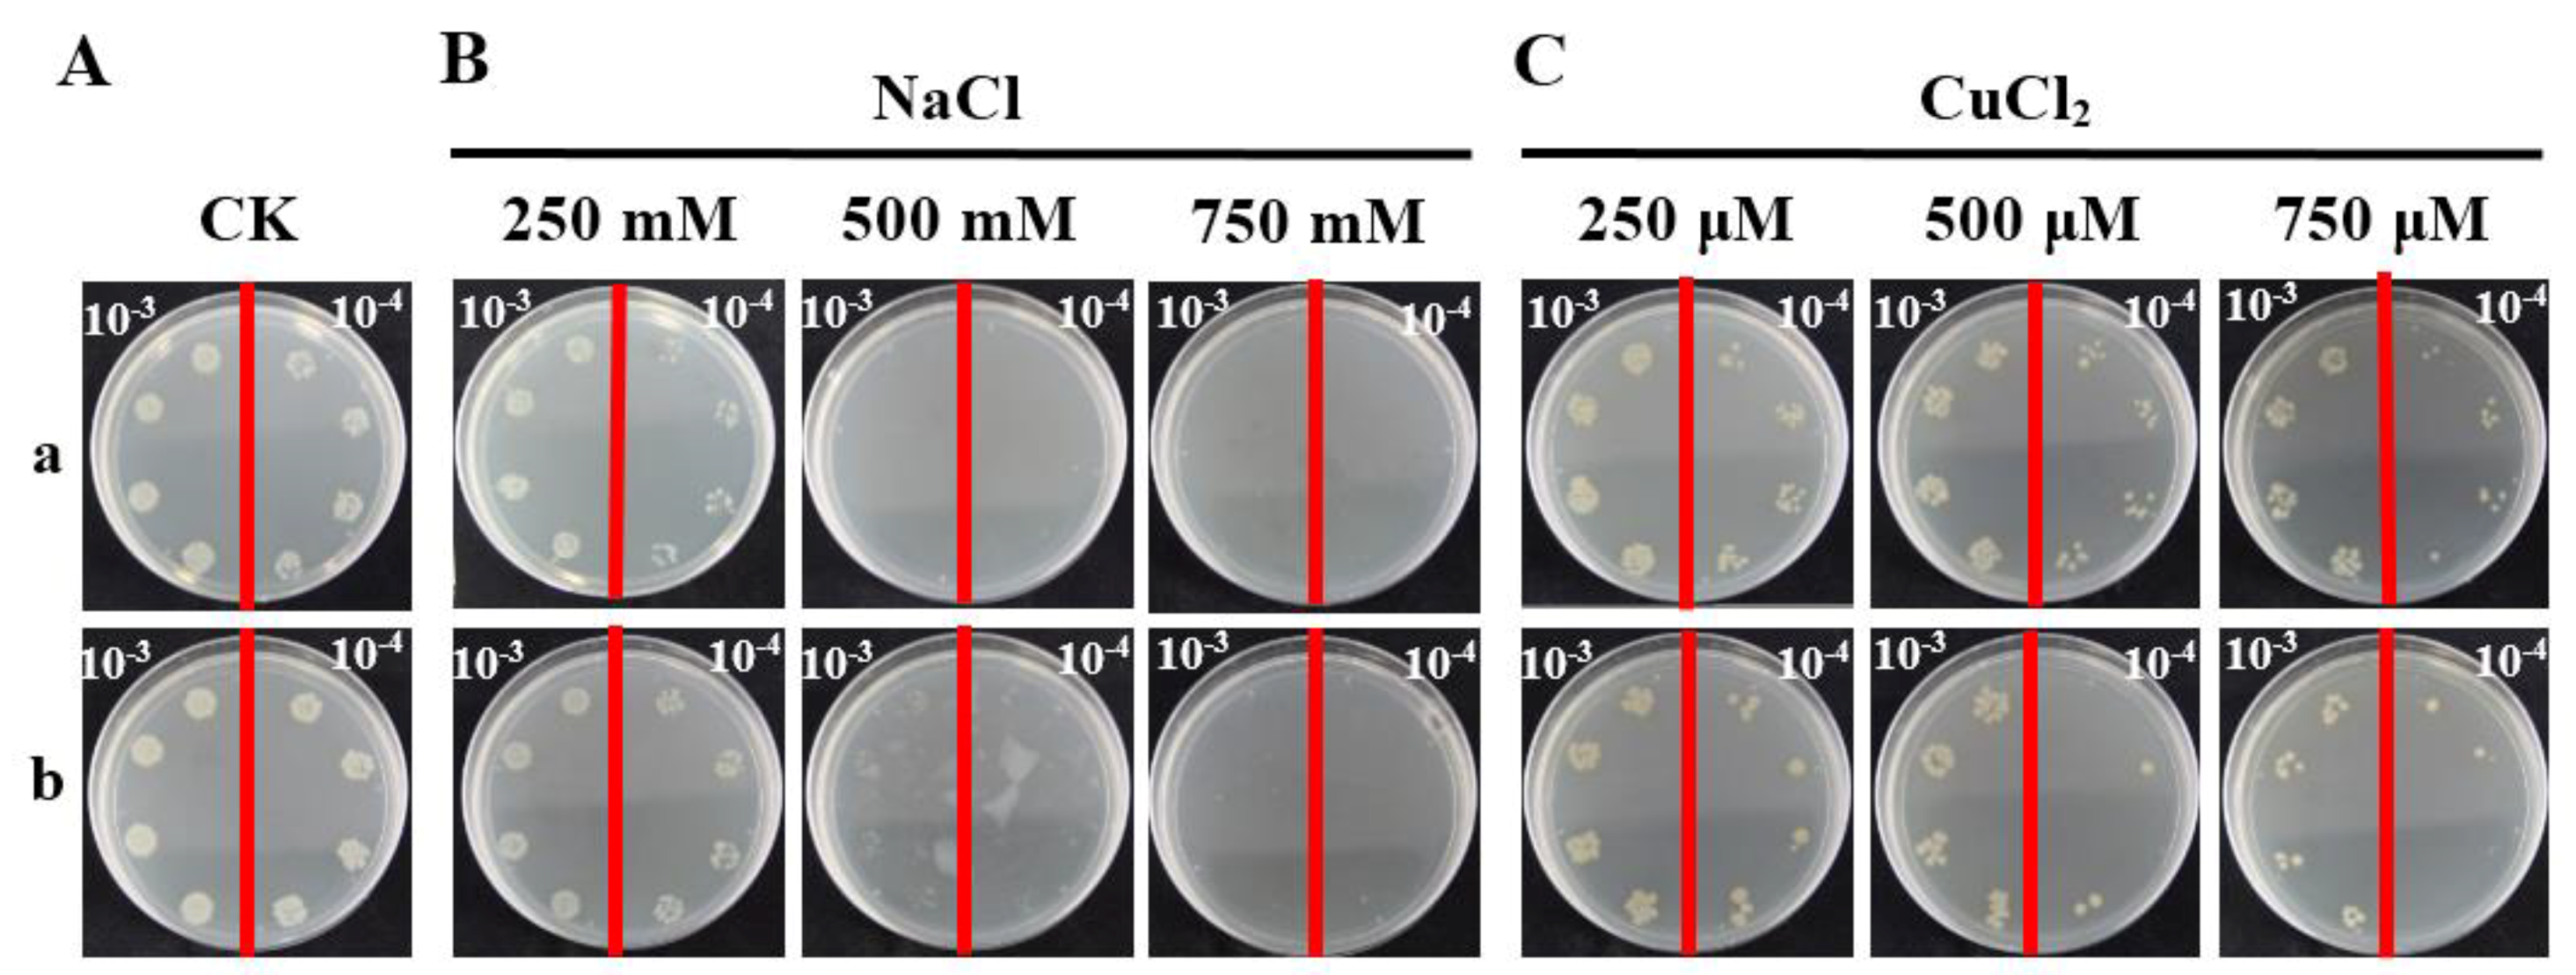
Ijms 19 02686 g008

The Role of Sugarcane Catalase Gene ScCAT2 in the Defense Response to Pathogen Challenge and Adversity Stress
Abstract
1. Introduction
2. Results
2.1. Cloning and Sequence Analysis of ScCAT2 Gene
2.2. Subcellular Localization of ScCAT2
2.3. Tissue-Specific Expression Analysis of ScCAT2
2.4. Analysis of the ScCAT2 Expression Patterns in Different Stress Conditions
2.5. Prokaryotic Expression Analysis of ScCAT2
2.6. Transient Expression of ScCAT2 in N. benthamiana-Induced Plant Immune Responses
3. Discussion
4. Materials and Methods
4.1. Plant Materials and Treatment Conditions
4.2. Total RNA Extraction and Synthesis of the First-Strand cDNA
4.3. Cloning of ScCAT2 Gene
4.4. Protein Structural Analysis and Phylogenetic Reconstruction
4.5. Subcellular Localization Assay
4.6. Quantification of ScCAT2 Expression by qRT-PCR Analysis
4.7. Prokaryotic Expression Assay
4.8. Transient Overexpression of ScCAT2 in N. benthamiana in Response to Pathogen Infection
5. Conclusions
Supplementary Materials
Author Contributions
Acknowledgments
Conflicts of Interest
References
- Willekens, H.; Inzé, D.; Montagu, M.V.; Camp, W.V. Catalases in plants. Mol. Breed. 1995, 1, 207–228. [Google Scholar] [CrossRef]
- Mhamdi, A.; Queval, G.; Chaouch, S.; Vanderauwera, S.; Van Breusegem, F.; Noctor, G. Catalase function in plants: A focus on Arabidopsis mutants as stress-mimic models. J. Exp. Bot. 2010, 61, 4197–4220. [Google Scholar] [CrossRef] [PubMed]
- Iwamoto, M.; Higo, H.; Higo, K. Differential diurnal expression of rice catalase genes: The 5′-flanking region of CatA, is not sufficient for circadian control. Plant Sci. 2000, 151, 39–46. [Google Scholar] [CrossRef]
- Redinbaugh, M.G.; Wadsworth, G.J.; Scandalios, J.G. Characterization of catalase transcripts and their differential expression in maize. Int. J. Biochem. Biophys. 1988, 951, 104–116. [Google Scholar] [CrossRef]
- Skadsen, R.W.; Schulze-Lefert, P.; Herbst, J.M. Molecular cloning, characterization and expression analysis of two catalase isozyme genes in barley. Plant Mol. Biol. 1996, 29, 1005–1014. [Google Scholar] [CrossRef]
- Saruyama, H.; Matsumura, T. Cloning and characterization of a cDNA encoding catalase in wheat. DNA Seq. 1999, 10, 31–35. [Google Scholar] [CrossRef] [PubMed]
- Guan, L.Q.; Scandalios, J.G. Developmentally related responses of maize catalase genes to salicylic acid. Proc. Natl. Acad. Sci. USA 1995, 92, 5930–5934. [Google Scholar] [CrossRef] [PubMed]
- Song, X.H. Research Progress on catalase in plants. Chin. J. Anhui Agric. Sci. 2007, 35, 9824–9827. [Google Scholar]
- Du, Y.Y.; Wang, P.C.; Chen, J.; Song, C.P. Comprehensive functional analysis of the catalase gene family in Arabidopsis thaliana. J. Integr. Plant Biol. 2008, 50, 1318–1326. [Google Scholar] [CrossRef] [PubMed]
- Scandalios, J.G.; Acevedo, A.; Ruzsa, S. Catalase gene expression in response to chronic high temperature stress in maize. Plant Sci. 2000, 156, 103–110. [Google Scholar] [CrossRef]
- Boldt, R.; Scandalios, J.G. Circadian regulation of the Cat3, catalase gene in maize (Zea mays L.): Entrainment of the circadian rhythm of Cat3, by different light treatments. Plant J. 1995, 7, 989–999. [Google Scholar] [CrossRef]
- Kwon, S.I.; Lee, H.; An, C.S. Differential expression of three catalase genes in the small radish (Rhaphanus sativus L. var. sativus). Mol. Cells 2007, 24, 37–44. [Google Scholar] [PubMed]
- Luna, C.M.; Pastori, G.M.; Driscoll, S.; Groten, K.; Bernard, S.; Foyer, C.H. Drought controls on H2O2 accumulation, catalase (cat) activity and cat gene expression in wheat. J. Exp. Bot. 2005, 56, 417–423. [Google Scholar] [CrossRef] [PubMed]
- Ma, C.L.; Wang, P.P.; Cao, Z.Y.; Zhao, Y.X.; Zhang, H. Cloning and differential gene expression of two catalases in Suaeda salsa in response to salt stress. J. Integr. Plant Biol. 2003, 45, 93–97. [Google Scholar]
- Guan, L.M.; Scandalios, J.G. Hydrogen-peroxide-mediated catalase gene expression in response to wounding. Free Radic. Biol. Med. 2000, 28, 1182–1190. [Google Scholar] [CrossRef]
- Mittler, R.; Herr, E.H.; Orvar, B.L.; Van, C.W.; Willekens, H.; Inzé, D.; Ellis, B.E. Transgenic tobacco plants with reduced capability to detoxify reactive oxygen intermediates are hyperresponsive to pathogen infection. Proc. Natl. Acad. Sci. USA 1999, 96, 14165–14170. [Google Scholar] [CrossRef] [PubMed]
- Purev, M.; Kim, Y.J.; Kim, M.K.; Pulla, R.K.; Yang, D.C. Isolation of a novel catalase (Cat1) gene from Panax ginseng and analysis of the response of this gene to various stresses. Plant Physiol. Biochem. 2010, 48, 451–460. [Google Scholar] [CrossRef] [PubMed]
- Lang, M.L.; Zhang, Y.X.; Chai, T.Y. Identification of genes up-regulated in response to Cd exposure in Brassica juncea L. Gene 2005, 363, 151–158. [Google Scholar]
- Yi, S.Y.; Yu, S.H.; Choi, D. Molecular cloning of a catalase cDNA from Nicotiana glutinosa L. and its repression by tobacco mosaic virus infection. Mol. Cells 1999, 9, 320–325. [Google Scholar] [PubMed]
- Yong, B.; Wang, X.Y.; Xu, P.; Zheng, H.Y.; Fei, X.T.; Hong, Z.X.; Ma, Q.Q.; Miao, Y.Z.; Yuan, X.H.; Jiang, Y.S.; et al. Isolation and abiotic stress resistance analyses of a catalase gene from Ipomoea batatas (L.) Lam. Biomed Res. Int. 2017, 2017, 6847532. [Google Scholar] [CrossRef] [PubMed]
- Frugoli, J.A.; Mcclung, C.R. Catalase is encoded by a multigene family in Arabidopsis thaliana (L.) Heynh. Plant Physiol. 1996, 112, 327–336. [Google Scholar] [CrossRef] [PubMed]
- Reilly, K.; Han, Y.; Tohme, J.; Beeching, J.R. Isolation and characterization of a cassava catalase expressed during post-harvest physiological deterioration 1. Gene Struct. Expr. 2001, 1518, 317–323. [Google Scholar] [CrossRef]
- Su, Y.C.; Guo, J.L.; Ling, H.; Chen, S.S.; Wang, S.S.; Xu, L.P.; Allan, A.C.; Que, Y.X. Isolation of a novel peroxisomal catalase gene from sugarcane, which is responsive to biotic and abiotic stresses. PLoS ONE 2014, 9, e84426. [Google Scholar] [CrossRef] [PubMed]
- Liu, Y.; Yao, Y.L.; Hu, X.W.; Xing, S.L.; Xu, L. Cloning and allelic variation of two novel catalase genes (SoCAT-1 and SsCAT-1) in Saccharum officinarum L. and Saccharum spontaneum L. Biotechnol. Biotechnol. Equip. 2015, 29, 431–440. [Google Scholar] [CrossRef]
- Liu, Y.; Hu, X.W.; Yao, Y.L.; Xu, L.; Xing, S.L. Isolation and expression analysis of catalase genes in Erianthus arundinaceus, and sugarcane. Sugar Tech 2016, 18, 468–477. [Google Scholar] [CrossRef]
- Zhang, J.S.; Zhang, Q.; Li, L.T.; Tang, H.B.; Zhang, Q.; Chen, Y.; Arro, J.; Zhang, X.T.; Wang, A.Q.; Miao, C.Y.; et al. Recent polyploidization events in three Saccharum founding species. Plant Biotechnol. J. 2018, 43, 847–852. [Google Scholar] [CrossRef] [PubMed]
- Iwamoto, M.; Higo, K. Accumulation of sense—Antisense transcripts of the rice catalase gene CatB under dark conditions requires signals from shoots. Gene 2006, 377, 186–194. [Google Scholar] [CrossRef] [PubMed]
- Modarresi, M.; Nematzadeh, G.A.; Moradian, F. Salinity response pattern and isolation of catalase gene from halophyte plant Aeluropus littoralis. Photosynthetica 2013, 51, 621–629. [Google Scholar] [CrossRef]
- Acevedo, A.; Williamson, J.D.; Scandalios, J.G. Photoregulation of the Cat2 and Cat3 catalase genes in pigmented and pigment-deficient maize: The circadian regulation of Cat3 is superimposed on its quasi-constitutive expression in maize leaves. Genetics 1991, 127, 601–607. [Google Scholar] [PubMed]
- Guan, L.Q.; Scandalios, J.G. Effects of the plant growth regulator abscisic acid and high osmoticum on the developmental expression of the maize catalase genes. Physiol. Plant. 1998, 104, 413–422. [Google Scholar] [CrossRef]
- Dong, C.; Zheng, X.F.; Diao, Y.; Wang, Y.W.; Zhou, M.Q.; Hu, Z.L. Molecular cloning and expression analysis of a catalase gene (Nncat) from Nelumbo nucifera. Appl. Biochem. Biotechnol. 2015, 177, 1216–1228. [Google Scholar] [CrossRef] [PubMed]
- Nie, Q.; Gao, G.L.; Fan, Q.J.; Qiao, G.; Wen, X.P.; Liu, T.; Peng, Z.J.; Cai, Y.Q. Isolation and characterization of a catalase gene “HuCAT3” from pitaya (Hylocereus undatus) and its expression under abiotic stress. Gene 2015, 563, 63–71. [Google Scholar] [CrossRef] [PubMed]
- Zimmermann, P.; Heinlein, C.; Orendi, G.; Zentgraf, U. Senescence-specific regulation of catalases in Arabidopsis thaliana (L.) heynh. Plant Cell Environ. 2006, 29, 1049–1060. [Google Scholar] [CrossRef] [PubMed]
- Ingram, J.; Bartels, D. The molecular basis of dehydration tolerance in plants. Annu. Rev. Plant Physiol. Plant Mol. Biol. 1996, 47, 377–403. [Google Scholar] [CrossRef] [PubMed]
- Zhou, Y.; Liu, S.Q.; Yang, Z.J.; Yang, Y.G.; Jiang, L.W.; Hu, L.F. CsCAT3, a catalase gene from Cucumis sativus, confers resistance to a variety of stresses to Escherichia coli. Biotechnol. Biotechnol. Equip. 2017, 31, 886–896. [Google Scholar] [CrossRef]
- Figueroayáñez, L.; Canososa, J.; Castaño, E.; Arroyoherrera, A.L.; Caamalvelazquez, J.H.; Sanchezteyer, F.; Lópezgómez, R.; Santosbriones, C.D.L.; Rodríguezzapata, L. Phylogenetic relationships and expression in response to low temperature of a catalase gene in banana (Musa acuminata cv. “Grand Nain”) fruit. Plant Cell Tissue Org. 2012, 109, 429–438. [Google Scholar] [CrossRef]
- Wutipraditkul, N.; Boonkomrat, S.; Buaboocha, T. Cloning and characterization of catalases from rice, Oryza sativa L. Biosci. Biotechnol. Biochem. 2014, 75, 1900–1906. [Google Scholar] [CrossRef] [PubMed]
- Ma, L.L.; Cui, G.F.; Wang, X.N.; Jia, W.; Duan, Q.; Du, W.W.; Wang, J.H. Cloning and expression analysis of catalase (Ls-Cat1) gene in Lilium sargentiae Wilson. Acta Agric. Nucl. Sin. 2017, 31, 1700–1707. [Google Scholar]
- Wang, S.P.; Yang, J.G.; Zhan, H.X.; Shen, L.L.; Qian, Y.M.; Wu, X.; Wang, F.L.; Li, X.H.; Chen, X.M.; Song, Y.C. Cloning of catalase gene (CAT1) and its expression patterns in Nicotiana tabacum L. Acta Tab. Sin. 2014, 20, 103–109. [Google Scholar]
- El-Awady, M.; Reda, E.A.M.; Haggag, W.; Youssef, S. Transgenic canola plants over-expressing bacterial catalase exhibit enhanced resistance to Peronospora parasitica and Erysiphe polygoni. Arab. J. Biotechnol. 2008, 11, 71–84. [Google Scholar]
- Yu, D.Q.; Xie, Z.X.; Chen, C.H.; Fan, B.F.; Chen, Z.X. Expression of tobacco class II catalase gene activates the endogenous homologous gene and is associated with disease resistance in transgenic potato plants. Plant Mol. Biol. 1999, 39, 477–488. [Google Scholar] [CrossRef] [PubMed]
- Polidoros, A.N.; Mylona, P.V.; Scandalios, J.G. Transgenic tobacco plants expressing the maize cat2 gene have altered catalase levels that affect plant-pathogen interactions and resistance to oxidative stress. Transgenic Res. 2001, 10, 555–569. [Google Scholar] [CrossRef] [PubMed]
- Choi, D.S.; Hwang, I.S.; Hwang, B.K. Requirement of the cytosolic interaction between pathogenesis-related protein 10 and leucine-rich repeat protein1 for cell death and defense signaling in pepper. Plant Cell 2012, 24, 1675–1690. [Google Scholar] [CrossRef] [PubMed]
- Dangl, J.L.; Dietrich, R.A.; Richberg, M.H. Death don’t have no mercy: Cell death programs in plant-microbe interactions. Plant Cell 1996, 8, 1793–1807. [Google Scholar] [CrossRef] [PubMed]
- Melechbonfil, S.; Sessa, G. Tomato MAPKKK epsilon is a positive regulator of cell-death signaling networks associated with plant immunity. Plant J. 2010, 64, 379–391. [Google Scholar] [CrossRef]
- Levine, A.; Tenhaken, R.; Dixon, R.; Lamb, C. H2O2 from the oxidative burst orchestrates the plant hypersensitive disease resistance response. Cell 1994, 79, 583–593. [Google Scholar] [CrossRef]
- Mani, T.; Manjula, S. Optimization of Agrobacterium-mediated transient gene expression and endogenous gene silencing in Piper colubrinum, Link. by vacuum infiltration. Plant Cell Tissue Org. 2011, 105, 113–119. [Google Scholar] [CrossRef]
- Hückelhoven, R.; Fodor, J.; Trujillo, M.; Kogel, K.H. Barley Mla and Rar mutants compromised in the hypersensitive cell death response against Blumeria graminis f. sp. hordei are modified in their ability to accumulate reactive oxygen intermediates at sites of fungal invasion. Planta 2000, 212, 16–24. [Google Scholar] [PubMed]
- Hwang, I.S.; Hwang, B.K. The pepper mannose-binding lectin gene CaMBL1 is required to regulate cell death and defense responses to microbial pathogens. Plant Physiol. 2011, 155, 447–463. [Google Scholar] [CrossRef] [PubMed]
- Scortecci, K.C.; Creste, S.; Calsa, T., Jr.; Xavier, M.A.; Landell, M.G.A.; Figueira, A.; Benedito, V.A. Challenges, opportunities and recent advances in sugarcane breeding. In Plant Breeding, 1st ed.; Abdurakhmonov, I., Ed.; InTech Publisher: Rijeka, Croatia, 2012; pp. 267–296. [Google Scholar]
- Garsmeur, O.; Droc, G.; Antonise, R.; Grimwood, J.; Potier, B.; Aitken, K.; Jenkins, J.; Martin, G.; Charron, C.; Hervouet, C.; et al. A mosaic monoploid reference sequence for the highly complex genome of sugarcane. Nat. Commun. 2018, 9, 2638. [Google Scholar] [CrossRef] [PubMed]
- Lakshmanan, P.; Geijskes, R.J.; Aitken, K.S.; Grof, C.L.P.; Bonnett, G.D.; Smith, G.R. Sugarcane biotechnology: The challenges and opportunities. In Vitro Cell. Dev. Biol. Plant 2005, 41, 345–363. [Google Scholar] [CrossRef]
- Srikanth, J.; Subramonian, N.; Premachandran, M.N. Advances in transgenic research for insect resistance in sugarcane. Trop. Plant Biol. 2011, 4, 52–61. [Google Scholar] [CrossRef]
- Gómez-Merino, F.C.; Trejo-Téllez, L.I.; Sentíes-Herrera, H.E. Sugarcane as a novel biofactory: Potentialities and challenges. In Biosystems Engineering: Biofactories for Food Production in the Century XXI, 2nd ed.; Guevara-Gonzalez, R., Torres-Pacheco, I., Eds.; Springer International Publishing: Cham, Switzerland, 2014; pp. 129–149. [Google Scholar]
- Shen, X.J.; Guo, X.W.; Guo, X.; Zhao, D.; Zhao, W.; Chen, J.S.; Li, T.H. PacMYBA, a sweet cherry R2R3-MYB transcription factor, is a positive regulator of salt stress tolerance and pathogen resistance. Plant Physiol. Biochem. 2017, 112, 302–311. [Google Scholar] [CrossRef] [PubMed]
- Kumar, M.; Choi, J.; An, G.; Kim, S.R. Ectopic expression of OsSta2 enhances salt stress tolerance in rice. Front. Plant Sci. 2017, 8, 316. [Google Scholar] [CrossRef] [PubMed]
- Su, Y.C.; Wang, Z.Q.; Xu, L.P.; Peng, Q.; Liu, F.; Li, Z.; Que, Y.X. Early selection for smut resistance in sugarcane using pathogen proliferation and changes in physiological and biochemical indices. Front. Plant Sci. 2016, 7, e84426. [Google Scholar] [CrossRef] [PubMed]
- Moosawijorf, S.A.; Izadi, M.B. In vitro detection of yeast-like and mycelial colonies of Ustilago scitaminea in tissue-cultured plantlets of sugarcane using polymerase chain reaction. J. Appl. Sci. 2007, 7, 3768–3773. [Google Scholar]
- Su, Y.C.; Xu, L.P.; Xue, B.T.; Wu, Q.B.; Guo, J.L.; Wu, L.G.; Que, Y.X. Molecular cloning and characterization of two pathogenesis-related β-1,3-glucanase genes ScGluA1 and ScGluD1 from sugarcane infected by Sporisorium scitamineum. Plant Cell Rep. 2013, 32, 1503–1519. [Google Scholar] [CrossRef] [PubMed]
- Liu, F.; Sun, T.T.; Wang, L.; Su, W.H.; Gao, S.W.; Su, Y.C.; Xu, L.P.; Que, Y.X. Plant jasmonate ZIM domain genes: Shedding light on structure and expression patterns of JAZ gene family in sugarcane. BMC Genom. 2017, 18, 771. [Google Scholar] [CrossRef] [PubMed]
- Chen, H.J.; Wu, S.D.; Huang, G.J.; Shen, C.Y.; Afiyanti, M.; Li, W.J.; Lin, Y.H. Expression of a cloned sweet potato catalase SPCAT1 alleviates ethephon-mediated leaf senescence and H2O2 elevation. J. Plant. Physiol. 2012, 169, 86–97. [Google Scholar] [CrossRef] [PubMed]
- Que, Y.X.; Xu, L.P.; Xu, J.S.; Zhang, J.S.; Zhang, M.Q.; Chen, R.K. Selection of control genes in real-time qPCR analysis of gene expression in sugarcane. Chin. J. Trop. Crop. 2009, 30, 274–278. [Google Scholar]
- Ling, H.; Wu, Q.B.; Guo, J.L.; Xu, L.P.; Que, Y.X. Comprehensive selection of reference genes for gene expression normalization in sugarcane by realtime quantitative RT-PCR. PLoS ONE 2014, 9, e97469. [Google Scholar] [CrossRef] [PubMed]
- Livak, K.J.; Schmittgen, T.D. Analysis of relative gene expression data using real-time quantitative PCR and the 2−∆∆CT method. Methods 2001, 25, 402–408. [Google Scholar] [CrossRef] [PubMed]
- Liu, F.; Huang, N.; Wang, L.; Ling, H.; Sun, T.T.; Ahmad, W.; Muhammad, K.; Guo, J.X.; Xu, L.P.; Gao, S.W.; et al. A novel l-ascorbate peroxidase 6 gene, ScAPX6, plays an important role in the regulation of response to biotic and abiotic stresses in sugarcane. Front. Plant Sci. 2018, 8, 2262. [Google Scholar] [CrossRef] [PubMed]

© 2018 by the authors. Licensee MDPI, Basel, Switzerland. This article is an open access article distributed under the terms and conditions of the Creative Commons Attribution (CC BY) license (http://creativecommons.org/licenses/by/4.0/).
Share and Cite
Sun, T.; Liu, F.; Wang, W.; Wang, L.; Wang, Z.; Li, J.; Que, Y.; Xu, L.; Su, Y. The Role of Sugarcane Catalase Gene ScCAT2 in the Defense Response to Pathogen Challenge and Adversity Stress. Int. J. Mol. Sci. 2018, 19, 2686. https://doi.org/10.3390/ijms19092686
Sun T, Liu F, Wang W, Wang L, Wang Z, Li J, Que Y, Xu L, Su Y. The Role of Sugarcane Catalase Gene ScCAT2 in the Defense Response to Pathogen Challenge and Adversity Stress. International Journal of Molecular Sciences. 2018; 19(9):2686. https://doi.org/10.3390/ijms19092686
Chicago/Turabian StyleSun, Tingting, Feng Liu, Wenju Wang, Ling Wang, Zhuqing Wang, Jing Li, Youxiong Que, Liping Xu, and Yachun Su. 2018. "The Role of Sugarcane Catalase Gene ScCAT2 in the Defense Response to Pathogen Challenge and Adversity Stress" International Journal of Molecular Sciences 19, no. 9: 2686. https://doi.org/10.3390/ijms19092686
APA StyleSun, T., Liu, F., Wang, W., Wang, L., Wang, Z., Li, J., Que, Y., Xu, L., & Su, Y. (2018). The Role of Sugarcane Catalase Gene ScCAT2 in the Defense Response to Pathogen Challenge and Adversity Stress. International Journal of Molecular Sciences, 19(9), 2686. https://doi.org/10.3390/ijms19092686

